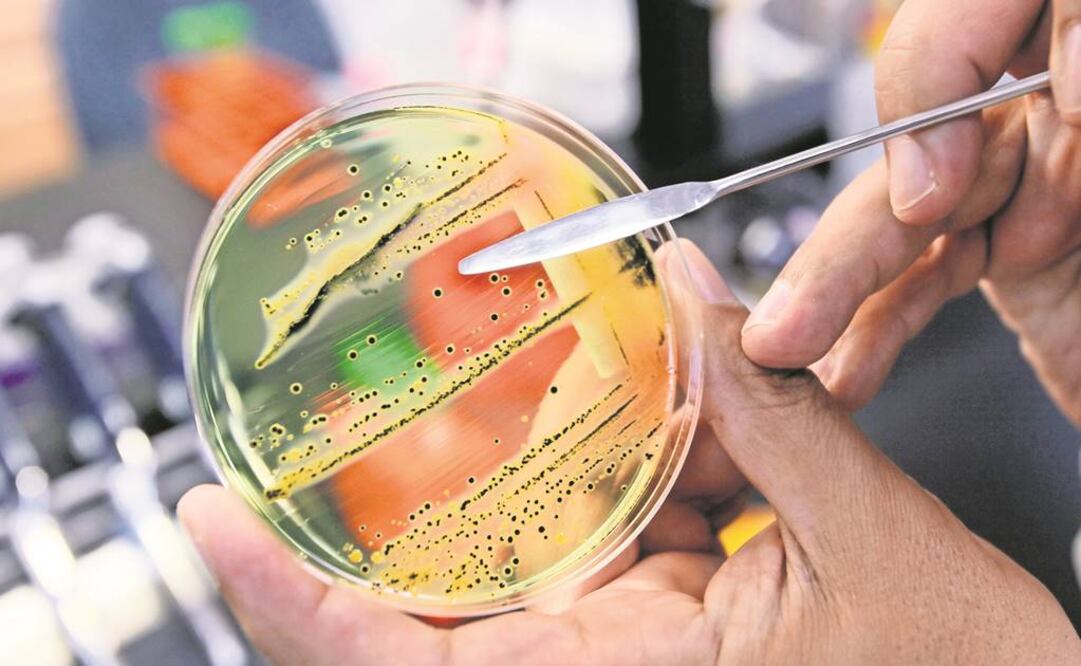
FOTO: Archivo.

[Publicidad]
Un equipo internacional de biólogos y antropólogos cree haber identificado la posible causa de una epidemia que provocó millones de muertos durante la época colonial en México.
De acuerdo con un estudio publicado este lunes en la revista científica Nature Ecology and Evolution , los científicos usaron nuevos métodos en la investigación de antiguas muestras de ADN para identificar la causa de muerte en los esqueletos de las víctimas de la epidemia cocoliztli registrada en México entre 1545 y 1550.
Los científicos, del Instituto Max Planck para la Ciencia de la Historia Humana (MPI-SHH) en Alemania, de la Universidad de Harvard en Estados Unidos y del Instituto Nacional de Antropología e Historia de México (INAH), determinaron que la epidemia pudo haber sido provocada por “Salmonella enterica Paratyphi C”, un patógeno que causa fiebre entérica.
La epidemia de cocoliztli causó millones de muertes en el territorio de Nueva España en el siglo XVI atribuidas a una o más enfermedades colectivamente llamadas cocoliztli. La causa de la epidemia había permanecido como desconocida, sin embargo, ahora el ADN de las víctimas cocolitzli del siglo XVI apunta a que esta fue provocada por Salmonella enterica , o la bacteria que causa la fiebre paratifoidea.
La evidencia de ADN proviene de los dientes de 11 personas enterradas en un gran cementerio mixteco en el estado de Oaxaca, en el sur de México. El trabajo arqueológico previo había vinculado los entierros en ese lugar a la epidemia de cocolitzli de 1545, y la ciudad probablemente fue abandonada después de que la enfermedad mató a muchos de sus habitantes.
"Los dientes son una excelente fuente de ADN", explico Kirsten Bos, antropóloga del Instituto Max Planck para la Ciencia de la Historia Humana, que trabajó en el nuevo estudio. La pulpa dental, el tejido blando y vivo dentro de los dientes, está llena de vasos sanguíneos y, por lo tanto, de cualquier patógeno que alguna vez haya circulado en la sangre. Y el esmalte duro en el exterior protege el ADN de esos patógenos durante siglos.
[Publicidad]
Bos y su equipo utilizaron un método llamado metagenómica que secuencia todo el ADN en una muestra, generando una larga lista de todas las bacterias presentes en los dientes. Los investigadores revisaron la lista a mano y apareció una cepa específica de Salmonella enterica repetidamente.
Las muestras de pulpa dental de cinco personas que murieron antes del contacto europeo pero que fueron enterradas en el mismo sitio no contenían cantidades significativas de Salmonella enterica. Los autores del estudio reconocen que la Salmonella enterica pudo haber interactuado con otros patógenos circulantes. El método no los descarta.
sc
[Publicidad]
[Publicidad]
Más información

Metrópoli
Bloquean Periférico Sur para exigir búsqueda de la enfermera Fátima Ozoara Cid desaparecida; demandan avances en la investigación

Metrópoli
Lluvias en CDMX dejan más de 42 millones de metros cúbicos de agua; autoridades atienden el 100% de los encharcamientos registrados

Metrópoli
Lluvias en CDMX; encharcamiento en Gran Canal deja vehículos varados en Gustavo A. Madero

Nación
Israel Vallarta confronta a Ciro Gómez Leyva en vivo; su esposa amenaza con demandarlo